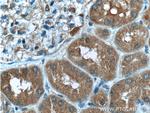
SDCCAG8 Antibody in Immunohistochemistry (Paraffin) (IHC (P))

Search
Proteintech
SDCCAG8 Monoclonal Antibody (2H1A4)
{{$productOrderCtrl.translations['antibody.pdp.commerceCard.promotion.promotions']}}
{{$productOrderCtrl.translations['antibody.pdp.commerceCard.promotion.viewpromo']}}
{{$productOrderCtrl.translations['antibody.pdp.commerceCard.promotion.promocode']}}: {{promo.promoCode}} {{promo.promoTitle}} {{promo.promoDescription}}. {{$productOrderCtrl.translations['antibody.pdp.commerceCard.promotion.learnmore']}}
产品信息
66284-1-IG
种属反应
宿主/亚型
分类
类型
克隆号
抗原
偶联物
形式
浓度
纯化类型
保存液
内含物
保存条件
运输条件
产品详细信息
Immunogen sequence: MAKSPENST LEEILGQYQR SLREHASRSI HQLTCALKEG DVTIGEDAPN LSFSTSVGNE DARTAWPELQ QSHAVNQLKD LLRQQADKES EVSPSRRRKM SPLRSLEHEE TNMPTMHDLV HTINDQSQYI HHLEAEVKFC KEELSGMKNK IQVVVLENEG LQQQLKSQRQ EETLREQTLL DASGNMHNSW ITTGEDSGVG ETSKRPFSHD NADFGKAASA GEQLELEKLK LTYEEKCEIE ESQLKFLRND LAEYQRTCED LKEQLKHKEF LLAANTCNRV GGLCLKCAQH EAVLSQTHTN VHMQTIERLV KERDDLMSAL VSVRSSLADT QQREASAYEQ VKQVLQISEE ANFEKTKHPS Q (1-360 aa encoded by BC032454)
靶标信息
SDCCAG8 (serologically defined colon cancer antigen 8), also known as CCCAP (centrosomal colon cancer autoantigen protein), HSPC085 or NY-CO-8, is a 713 amino acid cytoplasmic protein that is expressed in thymus, prostate, testis, ovary, small intestine, colon, mucosa and renal cancer tumors. Existing as a homodimer, SDCCAG8 localizes to centrioles and interacts with oral-facial-digital syndrome 1 (ODF1), which is associated with nephronophthisis-related ciliopathies (NPHP-RC), a recessive disorder that is characterized by dysplasia or degeneration of the kidney, retina and cerebellum. SDCCAG8 exists as four alternatively spliced isoforms and is encoded by a gene located on humanc chromosome 1, which spans 260 million base pairs, contains over 3,000 genes and comprises nearly 8% of the human genome.
仅用于科研。不用于诊断过程。未经明确授权不得转售。
篇参考文献 (0)
生物信息学
蛋白别名: Antigen NY-CO-8; Centrosomal colon cancer autoantigen protein; hCCCAP; Serologically defined colon cancer antigen 8
基因别名: BBS16; CCCAP; CCCAP SLSN7; hCCCAP; HSPC085; NPHP10; NY-CO-8; SDCCAG8; SLSN7
UniProt ID: (Human) Q86SQ7
Entrez Gene ID: (Human) 10806